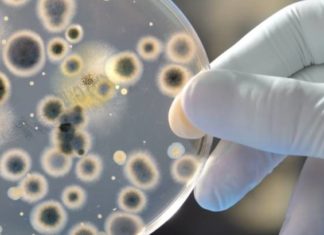

KORONAVIRUS (2019-nCov): Informacione ditore
Shkup, 21 Mars 2020 - Numri i përgjithshëm i pacientëve me koronavirus në vend deri në këtë moment është 76. Të gjithë pacientët, sipas deklaratave të djeshme të Ministrit të Shëndetësisë, Venko Filipce, kanë...
CORONAVIRUS (2019-nCov): Informacione ditore
Shkup, 19 Mars 2020 - Deri në mëngjesin e ditës së djeshme, në orën 08:00, janë regjistruar gjithsej 42 raste të personave të infektuar me koronavirus. Pardje u regjistruan 11 raste të reja, ndërsa...
Koronavirusi dhe sëmundjet tjera: Si të silleni nëse keni presion të lartë të gjakut,...
Supozojmë se jeni të frikësuar nëse i përkisni këtij grupi, kështu që ju sjellim disa këshilla se si të silleni.
KUSH BËN PJESË NË GRUPIN E RREZIKUT?
Për shkak të gjendjeve të caktuara shëndetësore, mund të...
Koronavirusi, gripi, alergjia apo ftohja? Përgjigjuni disa pyetjeve dhe zbuloni
Qendra Amerikane për Kontrollin e Sëmundjeve thekson se simptomat janë të lidhura me koronavirusin, megjithëse ato janë shumë të ngjashme, si rasti i ftohjes, gripit ose alergjive. Sidoqoftë, vështirësia në frymëmarrje besohet të jetë...
3 simptomat e koronavirusit që duhet t’i njihni
Sipas studimeve të deritanishme të rasteve, infeksioni COVID-19 në rreth 80% të rasteve shkakton sëmundje të lehtë (pa pneumoni ose inflamacion të lehtë të mushkërive) dhe shumica e të sëmurëve shërohen, 14% kanë sëmundje...
Sulmi i panikut apo infarkt? Mësoni si të njihni ndryshimet në simptomat
Këto dy gjendje kanë ngjashmëri dhe ndonjëherë janë të vështira për tu dalluar.
ÇFARË ËSHTË INFARKTI?
Kjo është gjendje e ndërlikimit më të rëndë të arteriosklerozës (sëmundje e zemrës) ku me bllokimin e plotë të njërës...
Për shkak të mungesës së simptomave, kanceri i pankreasit njihet edhe si sëmundje jashtëzakonisht...
Tumori i pankreasit quhet gjithashtu "sëmundje e heshtur" sepse simptomat rrallë herë shfaqen në fazë të hershme të sëmundjes. Testet që do të ndihmonin në zbulimin e hershëm, për fat të keq nuk janë...
Test i thjeshtë i gjakut mund të ndihmojë në diagnostikimin e tumori në tru
Një test i ri i thjeshtë i gjakut mund të ndihmojë mjekët e mjekësisë familjare, ose mjekët amë të diagnostikojë tumorin në tru, theksojnë shkencëtarët britanikë nga Universiteti Bristol.
Përndryshe, problemi me pacientët me tumor...
Çfarë dimë për viruset – si përhapen dhe pse ndonjëherë janë kaq të rrezikshme?
Viruset janë organizma mikroskopik që ekzistojnë kudo në tokë. Mund të infektohen njerëzit, kafshët, barishtet, bimët por madje edhe bakteret. Ndonjëherë, virusi është aq intensiv sa që mund të çojë deri në vdekje.
Virusi gjithashtu...
Kur mund të përhapet inflamacioni i fshikëzës edhe në veshka?
Meqenëse punojnë pa ndërprerje, nëpër to kalojnë 180 litra gjak çdo ditë. Kjo do të thotë se plazma jonë pastrohet 60 herë brenda ditës. Nga kjo sasi e madhe, 99% kthehet në qarkullim, ndërsa...